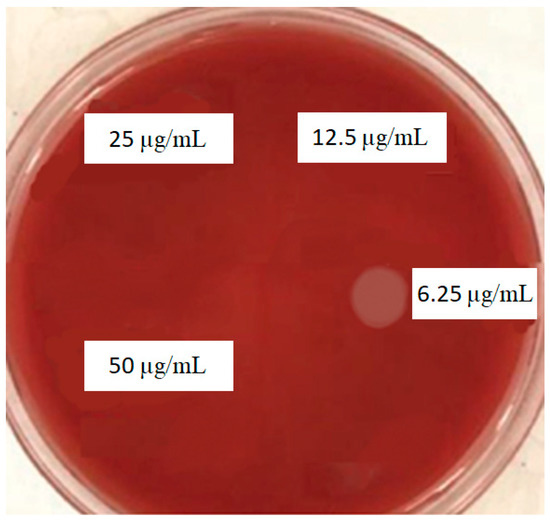

Abstract
Background. Despite their benefits, dental implants may sometimes fail for a diversity of causes; the most common reasons of failure are infection and bone loss. Porphyromonas gingivalis (P. gingivalis) bacteria show a major role in peri-implantitis infection and dental implant failure. Methods. In this study, the prevalence of P. gingivalis isolated from the gingival crevicular fluid (GCF) of fifteen Iranian patients with implant failure (more than 1/3 of the implant length), who had average oral and dental hygiene and no antibiotic use for at least one month, was determined. Moreover, the antimicrobial effects of curcumin nanocrystals against isolated P. gingivalis were investigated. The collected samples from patients were transferred to a microbiology laboratory to culture. The presence of P. gingivalis in the culture media was confirmed using a trypsin reagent test. An isolate from a patient with the highest colony count was selected to evaluate the antibacterial effects of curcumin nanoparticles. The inhibition zone diameter, minimum inhibitory concentration (MIC), and minimum bactericidal concentration (MBC) were determined. Results. Out of fifteen patients, eight (53.33%) were positive for the presence of P. gingivalis. The results of the microbial tests showed that curcumin nanoparticles had an MIC of 6.25 µg/mL and an MBC of 12.5 µg/mL. Conclusions. The use of curcumin nanoparticles may control the bacterial infection around the implant.
1. Introduction
After an implant is implanted into the jaw, it needs a healing time before the placement of a crown. Throughout this time, the implant fuses with the surrounding bone. This procedure is known as osseointegration [1,2].
Dental implants, despite their many advantages, may sometimes fail for a variety of reasons [3]. The implant has been shown to have consistently higher levels of inflammation than the natural tooth, which is why approving solutions capable of limiting this effect and keeping the health of peri-implant tissues for a long time is essential [4]. Peri-implantitis is an infectious disease that occurs around the implant and inside the gums. It is generally the outcome of poor dental hygiene following a dental implant procedure leading to more bone loss and implant failure [3,5]. In patients with low mandibular bone density or dental damage after implant surgery, implant failure may occur due to the lack of integration of the implant and jawbone [4]. The mechanical properties of the implant may also play a major role in implant failure [3,5]. Poor implant planning including implant design and diameter and occlusal overloading are the common variables related to implant fracture [5,6,7]. The wrong positioning, wrong prosthodontics plan, and too short biologic width also are other reasons for implant failure [3].
Recently, modern techniques of stem cell stimulation and bone neo-apposition with grafts are progressing; they also offer good opportunities in implant re-osseointegration. [8] To improve the stability and osseointegrations of implants, the dentistry industry uses a variety of scaffolds and growth factors [8,9]. Bioactive-molecule-loaded scaffolds show a main role in the promotion of stability and osseointegration in implants [8].
As mentioned, infection is known as one of the critical reasons in this regard [10,11]. Porphyromonas gingivalis (P. gingivalis) is recognized as one of the leading causes of dental implant failure [12]. Antibiotics are commonly used to control the infection of P. gingivalis [13]. The ineffectiveness of antibiotics against P. gingivalis is due to the alterations in the phenotype of the bacterium after its entry into the cells [13,14]. Clinical trials on periodontitis patients treated with antibiotics showed that the antibiotic therapy alone could not completely eliminate P. gingivalis [13]. Numerous side effects of synthetic antibiotics as well as the spread of drug resistance also lead to a tendency to use natural antimicrobials [11,15,16].
Curcumin is the active ingredient of turmeric plants and has powerful antimicrobial and anti-inflammatory properties. It is recognized for its medicinal properties such as anti-inflammatory, antioxidant, antimicrobial, hepatoprotective, immunostimulant, antiseptic, and antimutagenic [17]. Owing to these properties, it is a useful material in dentistry as well. It shows effectiveness in the treatment of periodontal diseases and oral cancers. It can also be applied as an active part in local drug delivery systems in gel form for dental uses. Curcumin or its nanoformulations can be used both in local and systemic forms [17,18].
A recent study showed that curcumin is very sensitive to P. gingivalis with the minimum inhibitory concentration (MIC) of 12 µg/mL [19]. Despite its unique properties, curcumin has minimal solubility in water. According to reports, nanocrystallization of curcumin or its loading into nanoparticles increases its solubility and antimicrobial potency [20,21].
In this study, we investigated the effects of curcumin nanocrystals on microbial contamination of P. gingivalis isolated from the gingival crevicular fluid (GCF) of Iranian patients with implant failure.
2. Materials and Methods
2.1. Ethical Considerations
The ethics code was received from the Ethics Committee of Tabriz University of Medical Sciences, and all steps were carried out after obtaining the code (IR.TBZMED.REC.1399.194). All participants filled out the written informed consent.
2.2. Materials
Curcumin powder was obtained from Sigma-Aldrich (Oakville, ON, Canada), and ethanol and hexane were purchased from Merck Company (Darmstadt, Germany). Thioglycolate broth, Brucella agar, defibrinated sheep blood, horse serum, vitamin K1, calcitonin antibiotic, trypsin reagent, amoxicillin, metronidazole, ciprofloxacin, amikacin, and gentamicin were purchased from Gibco, Ireland.
2.3. Methods
2.3.1. Preparation and Characterization of Curcumin Nanocrystals
Curcumin powder (80 mg) was dissolved in 10 mL of ethanol (Merck, Germany/Deutschland). Then, hexane (300 mL) was quickly added to the curcumin solution. A yellow suspension was obtained. The solvents were evaporated using a rotary evaporator (IKA®-Werke GmbH & Co- Germany/Deutschland). Finally, a spray drier (Shanghai, China/Shanghai) was used for spray-drying of curcumin nanocrystals by the following operation: an outlet temperature of 80 °C, inlet temperature of 150 °C, and liquid feed rate of 1.5 mL/min.
Characterization of Particle Size
A dynamic light scattering (DLS) device was used (Malvern, Worcestershire, England) for measuring the mean particle size of curcumin nanoparticles. The following operation was used for the DLS device: an argon laser beam at 633 nm and a 90° scattering angle at 25 °C.
Sample Size
The sample size was determined according to the results of Mombelli et al. [22] and considering the first type error (equal to 0.05) and the power of 80%. Then, a sample number equal to 15 was obtained.
2.3.2. Inclusion Criteria
The patients referred to the educational and therapeutic center of Tabriz University of Medical Sciences Dental School due to implant failure (more than 1/3 of the implant length), who had average oral and dental hygiene and had not used antibiotics for at least one month. The oral and dental hygiene status was determined using the simplified oral hygiene index (SOHI) based on the debris index (DIS) and the calculus index (CIS) and considering the participant’s age [23].
2.3.3. Exclusion Criteria
Patients with a history of smoking or drug addiction, those with a history of certain diseases or a history of taking certain drugs, and those whose oral and dental hygiene was very poor were excluded from the study.
2.3.4. Sampling of P. gingivalis
In this study, 15 patients with dental implant failure were selected according to the inclusion and exclusion criteria of the patients referred to the Department of Oral and Maxillofacial Surgery, Faculty of Dentistry, Tabriz University of Medical Sciences, Tabriz, Iran. First, the surface of the failed implant was cleaned with sterile gauze to remove salivary secretions and any other contamination. The patient’s gingival crevice fluid (from the failed implant) was then sampled using a sterile filter paper and placed in a thioglycollate broth culture medium. The samples were transferred to the microbiology laboratory in less than 30 min.
2.3.5. Microbiological Tests
The samples were vortexed for 30 s to separate the bacteria. A Brucella agar medium containing 5% defibrinated sheep blood, hemin, vitamin K1, bacitracin, colistin sulfate, and nalidixic acid was used for the isolation of bacteria. The plates were incubated for three days at 37 °C under anaerobic conditions. Then, the presence of P. gingivalis in the culture media was confirmed using a trypsin reagent test, which is a diagnostic test for P. gingivalis [24].
2.3.6. Sensitivity of Bacteria to Nanoparticles
The disk diffusion method was used to determine the sensitivity of P. gingivalis to the curcumin nanoparticles. First, a 0.5-McFarland suspension was prepared from the bacterial isolate, and then a uniform lawn culture was performed on the surface of Brucella agar supplemented with hemin (5 µg/mL), vitamin K1 (1 µg/mL), and laked sheep blood (5%). In the next step, sterile blank disks were immersed in the curcumin nanoparticle’s suspension (concentrations of 50, 25, 12.5, 6.25, and 3.12 µg/mL). The disks were placed on the agar surface. Antibiotic disks of metronidazole (5 µg/mL) were used as a positive control, and a blank disk immersed in water was used as a negative control. The plates were incubated for 42 h at 37 °C, and then the growth inhibition zones around the disks were measured.
2.3.7. Determination of MIC
To determine the MICs of the nanoparticles against P. gingivalis, broth microdilution method was performed using Brucella broth supplemented with hemin (5µg/mL), vitamin K1 (1 µg/mL), and lysed horse blood (5%) in the presence of a serial concentration of nanoparticles (50, 25, 12.5, and 6.25 µg/mL concentrations). Metronidazole antibiotic was used as a control (positive control). Wells containing water were considered as a negative control. The wells were incubated for 48 h at 35 °C and then examined for microbial growth turbidity. Visual turbidity detection was used to determine the MIC.
2.3.8. Determination of MBC
Ten microliters of the three pre-MIC wells was separately cultured on Brucella agar supplemented with hemin (5 µg/mL), vitamin K1 (1 µg/mL), and lysed sheep blood (5%). After 48 h, the lowest concentration of suspension in which the bacterium did not grow was reported as the MBC.
2.4. Statistical Data Analysis Method
The results were reported using descriptive statistics. In order to compare the antibacterial properties, one-way ANOVA was used. For data analysis, SPSS software version 2020 was used. A probability value of less than 0.05 was considered a significant level.
3. Results
3.1. Mean Particle Size of Curcumin Nanoparticles
The prepared curcumin nanoparticles exhibited a mean particle size of 95 nm (Figure 1).

Figure 1.
Distribution of particle size for prepared curcumin nanoparticles.
3.2. Prevalence of P. gingivalis in Selected Patients
Among the fifteen patients (eight men and seven women), eight patients (53.33%) were positive for the prevalence of P. gingivalis. Among the positive patients, five were men (62%) and three were women (38%). Two patients (25%) were in the age group of 20–35, two in the age group of 35–50, and four (50%) in the age group of 50–65 years old.
3.3. Sensitivity of P. gingivalis
The results of in vitro microbial tests showed that P. gingivalis was sensitive to the suspension of curcumin nanoparticles at concentrations of 50, 25, 12.5, and 6.25 µg/mL (Figure 2).

Figure 2.
Mean growth inhibition zone of curcumin nanoparticle and control antibiotic in disk diffusion test.
The results of the one-way ANOVA (between curcumin groups) showed that there is a significant difference between the curcumin groups for the mean growth inhibition zone, and curcumin nanocrystals with a concentration of 50 µg/mL showed the highest inhibition zone (p = 0.0003). In addition, the results of the one-way ANOVA (between all groups) showed that there is a significant difference between all groups for the mean growth inhibition zone, and metronidazole showed the highest inhibition zone (p = 0.0025).
3.4. Determination of MIC
Based on the MIC test, curcumin nanoparticles showed inhibitory effects against P. gingivalis at 6.25 µL/mL (Figure 3).

Figure 3.
MIC results for curcumin nanoparticles against P. gingivalis.
3.5. Determination of MBC
Based on the MBC test, curcumin nanoparticles showed bactericidal effects against P. gingivalis at 12.5 µL/mL (Figure 4).
Figure 4.
MBC results for curcumin nanoparticles against P. gingivalis.
4. Discussion
Implant failure is a dramatic problem that leads to prosthesis failures as well [18]. It can occur due to various reasons including infection, problems with mechanical possessions of the implant [5], poor implant planning [5,6,7], wrong positioning, wrong prosthodontics plan, and too short biologic width [3].
One of the main worries for the clinical use of curcumin is its low bioavailability. Furthermore, information about its safety in higher doses is so little. Nanotechnology-based new plans are being discovered to improve curcumin’s bioavailability and decrease its toxicity [3,25]. In this study, curcumin nanoparticles showed an MIC of 6.25 µg/mL and an MBC of 12.5 µg/mL against P. gingivalis. Our microbial results in this study were different from previous reports using P. gingivalis (ATCC33277). Mandroli and Bhat showed that the MIC of curcumin against P. gingivalis (ATCC33277) was 125 μg/mL [26]. Shahzad et al. [27] also reported that the growth of P. gingivalis (ATCC33277) was inhibited by curcumin at a concentration of 7.8 μg/mL, whereas Izui et al. [28] found that P. gingivalis growth was inhibited at 20 μg/mL of curcumin. A recent study also reported that P. gingivalis (ATCC33277) was sensitive to a curcumin concentration of 100 μg/mL [29]. The difference between the results of the above-mentioned studies and our study can be explained by the fact that they used free curcumin against standard bacteria, whereas we used curcumin nanoparticles against clinically isolated bacteria.
In two other studies, the MIC and MBC values for curcumin were equal against clinically isolated P. gingivalis. According to the authors, it can be explained by the fact that curcumin showed antibacterial activity against P. gingivalis instead of bacteriostatic activity [19,30].
Some reports showed that curcumin inhibits bacteria by damaging the bacterial membrane [31]. Curcumin has also been revealed to inhibit bacterial cell proliferation by perturbation of the FtsZ assembly. Other reports also confirmed that curcumin can meaningfully inactivate bacteria by inducing the production of ROS, including singlet oxygen and hydroxyl radicals [32,33].
Depending on the particle size and kind of bacteria, nanoparticles apply their antibacterial effects on bacteria by numerous mechanisms. The nanoparticles used in this study had an average particle size of 95 nm. Reports have shown the main role of physicochemical properties (size, shape, and surface properties) and doses of nanoparticles in their antimicrobial actions [34]. Nanoparticles can disorder bacteria cell membrane functions by binding to the surface of cell membranes with a high affinity compared with larger nanoparticles. This function is more predominant in smaller nanoparticles owing to their larger surface area [35,36]. The interaction of bacteria’s membrane and nanomaterials originates in the local pores in the membrane. The entry of the nanoparticles into the bacteria also leads to intracellular damage of proteins (particularly protein-rich in sulfur) and DNA. Nanomaterials can also bind to the bacterial membrane and slowly enter the cytoplasm to disrupt bacterial functions. Some antibiotic-loaded nanomaterials can also blend their structure with the bacterial cell wall and insert their drug material into the cytoplasm [21,37].
5. Conclusions
The use of curcumin nanoparticles may control the bacterial infection around the implant. However, more animal and clinical studies using different concentrations of curcumin and different formulations are needed to improve its ability to inhibit early periodontal pathogens in cases of chronic periodontitis and to increase the stability of implants for a longer period. Unfortunately, to date, some studies on the benefits of curcumin have inconclusive results. In addition, little information is available to determine its safety in higher doses. Therefore, further investigation is needed from this point of view as well.
6. Suggestions
The culture method is the gold standard method for P. gingivalis bacteria and is always recommended as the first diagnostic step. However, using the combined molecular method can help for the easy identification of P. gingivalis.
Author Contributions
Conceptualization, J.Y. and S.M.D.; data curation, H.S. and M.A.G.; formal analysis, S.S., S.M.D. and M.Y.M.; investigation, S.S., S.M.D., S.S. and M.Y.M.; methodology, J.Y., S.M.D., S.S. and M.A.G.; project administration, J.Y.; resources, S.M.D. and M.Y.M.; supervision, J.Y. and S.M.D.; validation, S.S. and H.S.; visualization, S.S. and M.A.G.; writing—original draft, S.S., S.M.D. and H.S.; writing—review and editing, J.Y., M.Y.M. and M.A.G. All authors have read and agreed to the published version of the manuscript.
Funding
This study was funded by the Vice-Chancellor for Research (VCR) of Tabriz University of Medical Sciences (grant number 64207).
Institutional Review Board Statement
The study was conducted in accordance with the Declaration of Helsinki, and approved by the Ethics Committee of the Tabriz University of Medical Sciences with a code of IR.TBZMED.REC.1399.194.
Informed Consent Statement
Informed consent was obtained from all subjects involved in the study and for publishing this paper.
Data Availability Statement
The raw/processed data can be shared by request from the corresponding author.
Acknowledgments
This study was based on a thesis (No. 64207) registered at the Faculty of Dentistry, Tabriz University of Medical Sciences, Tabriz, Iran. It was financially supported by the Vice-Chancellor for Research at Tabriz University of Medical Sciences, Tabriz, Iran, which is greatly acknowledged.
Conflicts of Interest
The authors state that there is no competing interest in this study.
References
- Desai, C.T.; Desai, S.J.; Marjadi, D.S.; Shah, G.S. Diminution of internal bacterial contamination of external dental implants using silver nanoparticles. Int. J. Agric. Sci. Res. Technol. 2018, 4, 115–119. [Google Scholar]
- Pournasrollah, A.; Negahdari, R.; Gharekhani, V.; Torab, A.; Ataei, S.J. Investigating the effect of abutment–implant connection type on abutment screw loosening in a dental implant system using finite element methods. J. Den. Res. Den. Clin. Dent. Prospect. 2019, 13, 289–292. [Google Scholar] [CrossRef]
- Tallarico, M.; Meloni, S.M.; Park, C.-J.; Zadrożny, Ł.; Scrascia, R.; Cicciù, M.J.P. Implant Fracture: A Narrative Literature Review. Prosthesis 2021, 3, 267–279. [Google Scholar] [CrossRef]
- Guarnieri, R.; Miccoli, G.; Reda, R.; Mazzoni, A.; Di Nardo, D.; Testarelli, L.J. Sulcus fluid volume, IL-6, and Il-1b concentrations in periodontal and peri-implant tissues comparing machined and laser-microtextured collar/abutment surfaces during 12 weeks of healing: A split-mouth RCT. Clin. Oral Implant. Res. 2022, 33, 94–104. [Google Scholar] [CrossRef]
- Zadrożny, Ł.; Czajkowska, M.; Tallarico, M.; Wagner, L.; Markowski, J.; Mijiritsky, E. Prosthetic Surgical Templates and Dental Implant Site Time Preparation: An In Vitro Study. Prosthesis 2022, 4, 25–37. [Google Scholar] [CrossRef]
- Ivanovski, S.; Bartold, P.M.; Huang, Y.S.J.P. The role of foreign body response in peri-implantitis: What is the evidence. Periodontol. 2000 2022, 11, 1–10. [Google Scholar] [CrossRef]
- Han, P.; Bartold, P.M.; Ivanovski, S.J. The emerging role of small extracellular vesicles in saliva and gingival crevicular fluid as diagnostics for periodontitis. J. Periodontal Res. 2022, 57, 219–231. [Google Scholar] [CrossRef]
- Sayed, M.E.; Mugri, M.H.; Almasri, M.A.; Al-Ahmari, M.M.; Bhandi, S.; Madapusi, T.B. Role of Stem Cells in Augmenting Dental Implant Osseointegration: A Systematic Review. Coatings 2021, 11, 1035. [Google Scholar] [CrossRef]
- Irastorza, I.; Luzuriaga, J.; Martinez-Conde, R.; Ibarretxe, G.; Unda, F. Adhesion, integration and osteogenesis of human dental pulp stem cells on biomimetic implant surfaces combined with plasma derived products. Eur. Cells Mater. 2019, 38, 201–214. [Google Scholar] [CrossRef]
- Schierholz, J.; Beuth, J. Implant infections: A haven for opportunistic bacteria. J. Hosp. Infect. 2001, 49, 87–93. [Google Scholar] [CrossRef]
- Shirmohammadi, A.; Chitsazi, M.T.; Lafzi, A. A clinical comparison of autogenous bone graft with and without autogenous periodontal ligament graft in the treatment of periodontal intrabony defects. Clin. Oral Investig. 2009, 13, 279–286. [Google Scholar] [CrossRef]
- Pier-Francesco, A.; Adams, R.J.; Waters, M.G.; Williams, D.W. Titanium surface modification and its effect on the adherence of Porphyromonas gingivalis: An in vitro study. Clin. Oral Implants Res. 2006, 17, 633–637. [Google Scholar] [CrossRef]
- Eick, S.; Pfister, W.J. Efficacy of antibiotics against periodontopathogenic bacteria within epithelial cells: An in vitro study. J. Periodontol. 2004, 75, 1327–1334. [Google Scholar] [CrossRef]
- Dufour, D.; Leung, V.; Lévesque, C.M.J.E.T. Bacterial biofilm: Structure, function, and antimicrobial resistance. Endod. Top. 2010, 22, 2–16. [Google Scholar] [CrossRef]
- Gajan, E.B.; Shirmohammadi, A.; Aghazadeh, M.; Alizadeh, M.; Deljavan, A.S.; Ahmadpour, F. Antibiotic resistance in Enterococcus faecalis isolated from hospitalized patients. J. Dent. Res. Dent. Clin. Dent. Prospect. 2013, 7, 102–104. [Google Scholar]
- Negahdari, R.; Bohlouli, S.; Sharifi, S.; Maleki Dizaj, S.; Rahbar Saadat, Y.; Khezri, K. Therapeutic benefits of rutin and its nanoformulations. Phytother. Res. 2021, 35, 1719–1738. [Google Scholar] [CrossRef]
- Checchi, V.; Grande, F.; Simone, S.; Tissino, B.; Ongaro, F.; Checchi, L. Relationships between curcuma and periodontitis: Literature overview. Dent. Cad. 2018, 86, 571–579. [Google Scholar] [CrossRef]
- Nagpal, M.; Sood, S.J. Role of curcumin in systemic and oral health: An overview. J. Nat. Sci. Biol. Med. 2013, 4, 3–7. [Google Scholar]
- Sha, A.M.; Garib, B.T. Antibacterial effect of curcumin against clinically isolated Porphyromonas gingivalis and connective tissue reactions to curcumin gel in the subcutaneous tissue of rats. BioMed Res. Int. 2019, 2019, 1–12. [Google Scholar] [CrossRef]
- Negahdari, R.; Ghavimi, M.A.; Barzegar, A.; Memar, M.Y.; Balazadeh, L.; Bohlouli, S.; Sharifi, S.; Dizaj, S.M. Antibacterial effect of nanocurcumin inside the implant fixture: An in vitro study. Clin. Exp. Dent. Res. 2021, 7, 163–169. [Google Scholar] [CrossRef]
- Negahdari, R.; Sharifi, S.; Ghavimi, M.A.; Memar, M.Y.; Khaneshi, B.; Dizaj, S.M.; Eftekhari, A.; Cucchiarini, M. Curcumin nanocrystals: Production, physicochemical assessment, and in vitro evaluation of the antimicrobial effects against bacterial loading of the implant fixture. App. Sci. 2020, 10, 8356. [Google Scholar] [CrossRef]
- Mombelli, A.; Lang, N.P.J.P. The diagnosis and treatment of peri-implantitis. Periodontol. 2000 1998, 17, 63–76. [Google Scholar] [CrossRef]
- Greene, J.G.; Vermillion, J.R. The simplified oral hygiene index. J. Am. Dent. Assoc. 1964, 68, 7–13. [Google Scholar] [CrossRef]
- Wikström, M.; Potempa, J.; Polanowski, A.; Travis, J.; Renvert, S. Detection of Porphyromonas gingivalis in gingival exudate by a dipeptide-enhanced trypsin-like activity. J. Periodontol. 1994, 65, 47–55. [Google Scholar] [CrossRef]
- Bisht, S.; Feldmann, G.; Soni, S.; Ravi, R.; Karikar, C.; Maitra, A. Polymeric nanoparticle-encapsulated curcumin (“ nanocurcumin”): A novel strategy for human cancer therapy. J. Nanobiotechnol. 2007, 5, 1–18. [Google Scholar] [CrossRef]
- Mandroli, P.S.; Bhat, K. An in-vitro evaluation of antibacterial activity of curcumin against common endodontic bacteria. J. Appl. Pharm. Sci. 2013, 3, 16–23. [Google Scholar]
- Shahzad, M.; Millhouse, E.; Culshaw, S.; Edwards, C.A.; Ramage, G.; Combet, E. Selected dietary (poly) phenols inhibit periodontal pathogen growth and biofilm formation. Food Funct. 2015, 6, 719–729. [Google Scholar] [CrossRef]
- IIzui, S.; Sekine, S.; Maeda, K.; Kuboniwa, M.; Takada, A.; Amano, A.; Nagata, H. Antibacterial activity of curcumin against periodontopathic bacteria. J. Periodontol. 2016, 87, 83–90. [Google Scholar] [CrossRef]
- Bomdyal, R.S.; Shah, M.U.; Doshi, Y.S.; Shah, V.A.; Khirade, S.P. Antibacterial activity of curcumin (turmeric) against periopathogens-An in vitro evaluation. J. Adv. Clin. Res. Insights 2017, 4, 175–180. [Google Scholar] [CrossRef]
- Bhatia, M.; Urolagin, S.S.; Pentyala, K.B.; Urolagin, S.B.; KB, M.; Bhoi, S. Novel therapeutic approach for the treatment of periodontitis by curcumin. J. Clin. Diagn. Res. 2014, 8, ZC65. [Google Scholar] [CrossRef]
- Shang, W.; Zhao, L.-J.; Dong, X.-L.; Zhao, Z.-M.; Li, J.; Zhang, B.-B.; Cai, H. Curcumin inhibits osteoclastogenic potential in PBMCs from rheumatoid arthritis patients via the suppression of MAPK/RANK/c-Fos/NFATc1 signaling pathways. Mol. Med. Rep. 2016, 14, 3620–3626. [Google Scholar] [CrossRef]
- Cirano, F.; Pimentel, S.; Casati, M.; Corrêa, M.; Pino, D.; Messora, M.; Silva, P.; Ribeiro, F. Effect of curcumin on bone tissue in the diabetic rat: Repair of peri-implant and critical-sized defects. Int. J. Oral Maxillofac. Surg. 2018, 47, 1495–1503. [Google Scholar] [CrossRef]
- Xu, C.; Ip, M.; Leung, A.; Wang, X.; Yang, Z.; Zhang, B.; Ip, S.P. Sonodynamic bactericidal activity of curcumin against foodborne bacteria. Hong Kong Med. J. 2018, 24, 43–44. [Google Scholar]
- Marambio-Jones, C.; Hoek, E.M. A review of the antibacterial effects of silver nanomaterials and potential implications for human health and the environment. J. Nanopart. Res. 2010, 12, 1531–1551. [Google Scholar] [CrossRef]
- Dizaj, S.M.; Lotfipour, F.; Barzegar-Jalali, M.; Zarrintan, M.H.; Adibkia, K. Antimicrobial activity of the metals and metal oxide nanoparticles. Mater. Sci. Eng. C 2014, 44, 278–284. [Google Scholar] [CrossRef]
- Salatin, S.; Maleki Dizaj, S.; Yari Khosroushahi, A. Effect of the surface modification, size, and shape on cellular uptake of nanoparticles. Cell Biol. Int. 2015, 39, 881–890. [Google Scholar] [CrossRef]
- Samiei, M.; Farjami, A.; Dizaj, S.M.; Lotfipour, F. Nanoparticles for antimicrobial purposes in Endodontics: A systematic review of in vitro studies. Mater. Sci. Eng. 2016, 58, 1269–1278. [Google Scholar] [CrossRef]
Publisher’s Note: MDPI stays neutral with regard to jurisdictional claims in published maps and institutional affiliations. |
© 2022 by the authors. Licensee MDPI, Basel, Switzerland. This article is an open access article distributed under the terms and conditions of the Creative Commons Attribution (CC BY) license (https://creativecommons.org/licenses/by/4.0/).